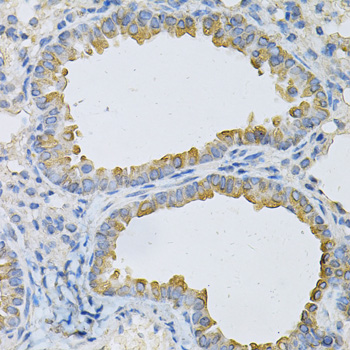
Immunohistochemistry - AP2B1 Polyclonal Antibody

-
Product Name
AP2B1 Polyclonal Antibody
- Documents
-
Description
Polyclonal antibody to AP2B1
-
Tested applications
WB, IHC
-
Species reactivity
Human, Mouse
-
Alternative names
AP2B1 antibody; ADTB2 antibody; AP105B antibody; AP2-BETA antibody; CLAPB1 antibody; AP-2 complex subunit beta antibody
-
Isotype
Rabbit IgG
-
Preparation
Antigen: Recombinant fusion protein containing a sequence corresponding to amino acids 752-951 of human AP2B1 (NP_001025177.1).
-
Clonality
Polyclonal
-
Formulation
PBS with 0.02% sodium azide, 50% glycerol, pH7.3.
-
Storage instructions
Store at -20℃. Avoid freeze / thaw cycles.
-
Applications
WB 1:500 - 1:2000
IHC 1:50 - 1:200 -
Validations

Western blot - AP2B1 Polyclonal Antibody
Western blot analysis of extracts of various cell lines, using AP2B1 antibody at 1:1000 dilution.Secondary antibody: HRP Goat Anti-Rabbit IgG (H+L) at 1:10000 dilution.Lysates/proteins: 25ug per lane.Blocking buffer: 3% nonfat dry milk in TBST.Detection: ECL Basic Kit .Exposure time: 30s.

Immunohistochemistry - AP2B1 Polyclonal Antibody
Immunohistochemistry of paraffin-embedded human esophagus using AP2B1 Antibody at dilution of 1:100 (40x lens).
Immunohistochemistry - AP2B1 Polyclonal Antibody
Immunohistochemistry of paraffin-embedded mouse lung using AP2B1 Antibody at dilution of 1:100 (40x lens).

Immunohistochemistry - AP2B1 Polyclonal Antibody
Immunohistochemistry of paraffin-embedded mouse stomach using AP2B1 Antibody at dilution of 1:100 (40x lens).
-
Background
Component of the adaptor protein complex 2 (AP-2). Adaptor protein complexes function in protein transport via transport vesicles in different membrane traffic pathways. Adaptor protein complexes are vesicle coat components and appear to be involved in cargo selection and vesicle formation. AP-2 is involved in clathrin-dependent endocytosis in which cargo proteins are incorporated into vesicles surrounded by clathrin (clathrin-coated vesicles, CCVs) which are destined for fusion with the early endosome. The clathrin lattice serves as a mechanical scaffold but is itself unable to bind directly to membrane components. Clathrin-associated adaptor protein (AP) complexes which can bind directly to both the clathrin lattice and to the lipid and protein components of membranes are considered to be the major clathrin adaptors contributing the CCV formation. AP-2 also serves as a cargo receptor to selectively sort the membrane proteins involved in receptor-mediated endocytosis. AP-2 seems to play a role in the recycling of synaptic vesicle membranes from the presynaptic surface. AP-2 recognizes Y-X-X-[FILMV] (Y-X-X-Phi) and [ED]-X-X-X-L-[LI] endocytosis signal motifs within the cytosolic tails of transmembrane cargo molecules. AP-2 may also play a role in maintaining normal post-endocytic trafficking through the ARF6-regulated, non-clathrin pathway. The AP-2 beta subunit acts via its C-terminal appendage domain as a scaffolding platform for endocytic accessory proteins; at least some clathrin-associated sorting proteins (CLASPs) are recognized by their [DE]-X(1,2)-F-X-X-[FL]-X-X-X-R motif. The AP-2 beta subunit binds to clathrin heavy chain, promoting clathrin lattice assembly; clathrin displaces at least some CLASPs from AP2B1 which probably then can be positioned for further coat assembly.
Related Products / Services
Please note: All products are "FOR RESEARCH USE ONLY AND ARE NOT INTENDED FOR DIAGNOSTIC OR THERAPEUTIC USE"
